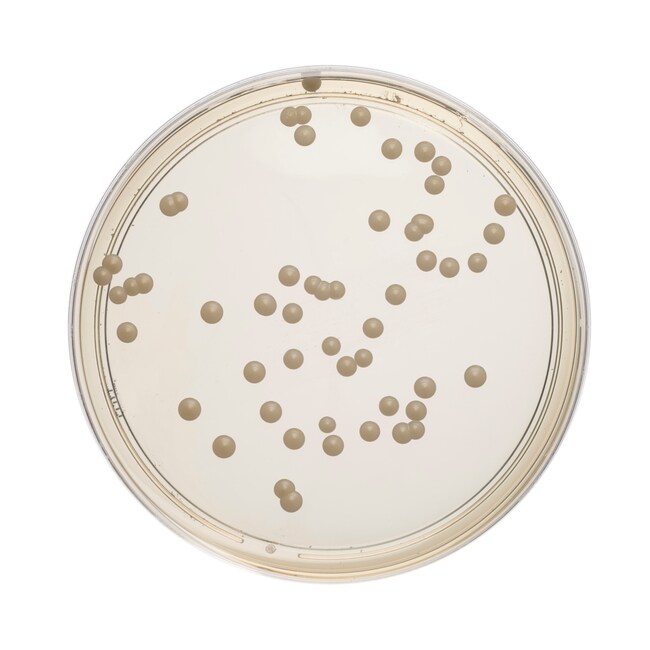
Sabouraud Dextrose Agar with Chloramphenicol

Search
Search
| 货号 | 数量 | 产品规格 | 培养基类型 | 容纳重量 |
|---|---|---|---|---|
| PO0161A | 10/Pk. | 90mm Monoplate | SDA with CAM | 19.5 g ± 1.0 g |
Isolate, cultivate and differentiate dermatophytes, fungi and yeasts, such as Candida albicans, using acidic pH Thermo Scientific™ Sabouraud Dextrose Agar with Chloramphenicol.
Fungi maintain their typical cultural appearance and may thus be readily identified according to the standard macroscopic characteristics. Infections caused by Candida spp. are diverse, ranging from superficial and local to deep-seated and disseminated. Candida albicans and Candida glabrata comprise 70 to 80% of yeast isolates recovered from patients with invasive disease.
This culture media, also available in powder form, has applications in environmental monitoring and sterility testing, enabling corrective measures to be implemented rapidly if unacceptable levels of microbial loading indicate lapses in process control.
Not all products are available for sale in all territories. Please inquire.
Remel™ and Oxoid™ products are now part of the Thermo Scientific brand.